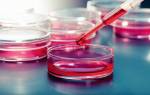

Сегодня одним из самых задаваемых вопросов счастливых обладателей двух и более детей является вопрос о дальнейшей судьбе закона, который позволяет этим родителям получить финансовую поддержку от государства.
Принимая во внимание сложившиеся экономические трудности в стране, по многим государственным социальным программам их дальнейшая судьба широко и довольно бурно обсуждается в Российском обществе повсеместно: в СМИ, интернете, радио и телевидении, в социально ориентированных государственных и общественных организациях, Правительстве. Жаркие дебаты не обошли стороной и высшие законодательные органы власти – Государственную Думу и Совет Федерации. Вполне логично и закономерно вопрос о судьбе «материнского капитала» не обошел своего внимания и в решениях, принимаемых Президентом РФ.
И так, что мы имеем по нашему вопросу по состоянию на 2016 год?
В начале разберемся со сроками действия интересующей нас программы. А своё действие она начала с момента её принятия, то есть с 1 января 2007 года и была рассчитана и соответственно профинансирована бюджетом страны на полные десять лет. Согласно закону Российской Федерации «О дополнительных мерах государственной поддержки семей, имеющих детей», принятому Государственной Думой 22.12.2006 года (с внесёнными дополнениями и изменениями в последующие годы), срок действия программы должен был закончиться 31 декабря 2016 года.
По поручению Президента РФ В.В. Путина выдача сертификатов на материнский капитал после 31 декабря текущего года продлена до 31 декабря 2018 года, то есть ещё на два года. В результате, 30.12.2015 года был принят Федеральный закон №433-ФЗ и в Программу были внесены соответствующие изменения.
Теперь мы можем резюмировать, с учётом вышесказанного, что на помощь по программе «Материнский капитал» могут рассчитывать российские семьи, которые ранее не оформляли право на «материнский капитал», в которых есть второй, третий или последующие дети, рожденные в период с 2007 по 2018 годы.
Что касается суммы по сертификату, то она в 2016 году составит 453 тысячи 026 рублей, то есть останется на уровне прошлого года, так как по решению Правительства её размер не будет проиндексированы.
С чем это связано?
На протяжении всего периода действия программы размер выплат индексировался регулярно. Так, в 2007 году материнский капитал составлял всего лишь 250 000 руб., но уже к 2015 году размер предоставляемой суммы увеличился на 81% от базового размера, то есть – до 453 026 рублей.
Однако, как мы ранее заметили, в 2016 году в связи с тяжелым положением в экономике страны, Правительство России приняло решение не проводить очередную индексацию суммы по сертификату.
Тем не менее, в Государственной Думе Российской Федерации обсуждается ряд поправок в закон, согласно которым в последующем размер выплаты по материнскому капиталу будет все же увеличен, ориентировочно с января следующего года при условии стабилизации в экономике и имеющихся возможностей бюджета страны в будущем.
Например, один из законопроектов предусматривает повышение суммы материнского капитала на 6 процентов или в абсолютных цифрах, до 480 000 рублей.
В новой редакции Федерального закона субъектами, имеющими право на получение семейного капитала, являются: женщины, родившие второго (третьего, четвертого и последующего) ребенка, а также женщины, усыновившие второго (третьего, четвертого и последующего) ребенка; мужчины, которые имеют статус единственного усыновителя второго (третьего, четвертого и последующего) ребенка; отцы или усыновители второго (третьего, четвертого и последующего) ребенка, если мать или усыновительница данного ребенка утратила свое право на капитал; и наконец, сам ребёнок, если его родители (усыновители) утратили свое право на получение федерального материнского капитала.
Кроме того, с 01.01.2016 года было принято ещё одно существенное изменение в Программе «Материнский капитал». Поправка касается расширения основных направлений его использования. В частности, к трем ранее существовавшим направлениям использования материнского капитала было добавлено ещё одно. Теперь финансовые средства, полученные по сертификату материнского капитала можно направлять также на социальную адаптацию и интеграцию в общество детей-инвалидов независимо от времени, прошедшего с момента их рождения или усыновления, то есть, не дожидаясь 3 лет.
И последнее. В настоящий момент в Правительстве РФ рассматривается возможность повторного получения единовременной выплаты из средств материнского капитала в размере 20 000 рублей в рамках принимаемых антикризисных мер. Также обсуждается проект, согласно которому может быть предоставлена дополнительная ежемесячная выплата в размере 5 000 рублей в период с июня 2016 года по май 2017 года.
Речь идет о реализации закона от 20.04.2015 г. №88-ФЗ в последующем периоде, согласно которому семьи с детьми, получившие право на материнский капитал до 31.12.2015 года и еще не израсходовавшие целиком предусматриваемую сертификатом сумму, могут обратиться в ПФР с заявлением на получение единовременной выплаты 20000 руб. в срок до 31.03.2016 года.
Таким образом, отвечая на вопрос, «когда же можно будет получить эту сумму?», можно предположить, что после 31 марта текущего года в рамках нового закона, разработка и принятие которого ожидается в ближайшее время, еще в течение одного года в срок до 31.03.2017 г. появится право обратиться в Пенсионный фонд РФ, написав повторное заявление , по которому (в случае принятия положительного решения) в течение 2 месяцев в качестве единовременной меры поддержки на банковский счет заявителя будут перечислены повторно денежные средства в размере 20 000 рублей и сумма неизрасходованного остатка меньшего размера.
Завершая обзор законодательства, касающегося последних изменений в государственной программе «Материнский капитал» в 2016 году, важно напомнить, что ответственным модератором её исполнения выступает Пенсионный фонд России. Нашим читателям рекомендуем посетить официальный его сайт, чтобы детально ознакомиться с условиями участия в программе и задать интересующие вопросы.
Автор статьи: Валерий Квасов, экспертный юрист
Мнение врача:
Врачи отмечают, что выплаты государственной субсидии по программе «Материнский капитал» в 2016 году имеют положительное влияние на матери и детей. Эта программа способствует улучшению социального благополучия семей, поощряя рождение и воспитание детей. Благодаря выплатам материнского капитала многие семьи могут обеспечить детям лучшие условия для развития и образования. Врачи отмечают, что такие государственные меры способствуют укреплению здоровья и благополучия детей, что в долгосрочной перспективе положительно сказывается на здоровье нации в целом.
Опыт других людей
В 2016 году многие российские семьи оставались довольными выплатами государственной субсидии в рамках программы “Материнский капитал”. Многие родители отмечали значительную помощь со стороны государства, которая позволяла облегчить финансовую нагрузку при воспитании детей. Отзывы о программе были в основном положительные: семьи высказывали благодарность за возможность использовать средства на улучшение жилищных условий, образование детей или инвестирование в будущее. Некоторые отмечали улучшение социального положения благодаря полученной субсидии. В целом, программа “Материнский капитал” в 2016 году продолжала оставаться одной из наиболее популярных и востребованных форм государственной поддержки семей в России.

Частые вопросы
Можно ли получить материнский капитал на ребенка 2016 года?
Материнский капитал может получить женщина, родившая или усыновившая: первого ребёнка с 1 января 2020 года второго ребёнка с 1 января 2007 года третьего или последующего ребёнка с 1 января 2007 года
Как сделать индексацию материнского капитала?
Сумму маткапитала и других выплат проиндексируют в беззаявительном порядке с 1 февраля. Переоформлять пособия не нужно. Уточнить точный размер индексации в вашем случае можно в МФЦ или в справочной службе Соцфонда.
Сколько сейчас составляет материнский капитал полученный в 2017 году?
В 2017, 2018 и 2019 годах он составлял 453 026,00 руб. В 2020 году установлены следующие размеры маткапитала: если право на материнский капитал возникло до 31 декабря 2019 года – 466 617 руб., если в семье после 1 января 2020 года родится (будет усыновлен) первый ребенок – 466 617 руб.
Полезные советы
СОВЕТ №1
Проверьте свою право на получение материнского капитала. Уточните, соответствуете ли вы всем требованиям программы, чтобы избежать недоразумений при подаче заявления.
СОВЕТ №2
Ознакомьтесь с процедурой подачи заявления на получение материнского капитала. Узнайте, какие документы необходимо предоставить и в какие сроки это нужно сделать.
СОВЕТ №3
Следите за изменениями в законодательстве. Правила получения материнского капитала могут меняться, поэтому важно быть в курсе последних обновлений, чтобы не упустить свои возможности.